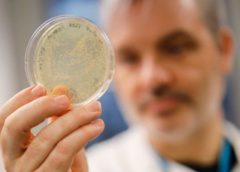

Classificando o novo coronavírus como uma pandemia ou não, o problema é grave. Não dá para minimizar a importância. Em menos de dois meses, ele se espalhou por vários continentes.
Uma pandemia implica uma transmissão sustentada, eficaz e contínua da doença simultaneamente em mais de três regiões geográficas diferentes. Já podemos estar nesta fase, mas isso não é sinônimo de morte, pois o termo não se refere à taxa de mortalidade do agente infeccioso, mas à sua transmissibilidade e extensão geográfica.
O que certamente existe é uma pandemia de medo. Pela primeira vez na história, estamos enfrentando uma epidemia em tempo real: toda a mídia, várias vezes ao dia, todos os dias, em todo o planeta, fala sobre o novo coronavírus, que causa a doença covid-19.
Seguimos a identificação de cada caso ao vivo. Foi notícia de primeira página que o vírus no Brasil sofreu mutação três vezes!
Insisto: o assunto é sério, mas uma das primeiras vítimas do coronavírus na Espanha foi o Ibex35 (a bolsa de Madri). É necessário informar o que está acontecendo, mas também precisamos de boas notícias. Aqui estão dez delas.
1. Sabemos quem é
Os primeiros casos de Aids foram descritos em junho de 1981 e foram necessários mais de dois anos para identificar o vírus causador da doença. Os primeiros casos do novo coronavírus foram relatados na China em 31 de dezembro de 2019 e em 7 de janeiro o vírus já havia sido identificado.
O genoma estava disponível no dia 10. Já sabemos que é um novo coronavírus do grupo 2B, da mesma família que a Sars, razão pela qual o chamamos de SARSCoV2. A doença é chamada covid-19.
Está relacionado ao coronavírus de morcegos. As análises genéticas confirmam que ela tem uma origem natural recente (entre o final de novembro e o início de dezembro) e que, embora os vírus sofram mutações, sua frequência de mutação não é muito alta.
2. Sabemos como detectá-lo
Desde 13 de janeiro está disponível para todo o mundo um teste de RT-PCR para detectar o vírus.
Nos últimos meses, esses tipos de testes foram aperfeiçoados e tiveram sua sensibilidade e especificidade avaliadas.
3. Na China, a situação está melhorando
As fortes medidas de controle e isolamento impostas pela China estão gerando resultado. Há semanas, o número de casos diagnosticados diminui a cada dia.
Em outros países, está sendo realizado um acompanhamento epidemiológico muito detalhado. Os focos são muito concretos, o que permite que eles sejam controlados mais facilmente. Por exemplo, na Coreia do Sul e em Cingapura.
4. 81% dos casos são leves
A doença não causa sintomas ou é leve em 81% dos casos.
Em 14%, pode causar pneumonia grave e em 5% pode se tornar crítica ou letal.
5. Cura
Os únicos dados que às vezes são mostrados na mídia são o aumento no número de casos confirmados e no número de mortes, mas a maioria das pessoas infectadas é curada.
Há 13 vezes mais pacientes curados do que mortos, e a proporção está aumentando.
6. Quase não afeta menores de idade
Apenas 3% dos casos ocorrem em menores de 20 anos e a mortalidade em menores de 40 anos é de apenas 0,2%.
Nas crianças, os sintomas são tão leves que podem passar despercebidos.
7. O vírus é facilmente inativado
O vírus pode ser inativado das superfícies com uma solução de etanol (álcool 62-71%), peróxido de hidrogênio (água oxigenada a 0,5%) ou hipoclorito de sódio (lixívia a 0,1%), em apenas um minuto.
A lavagem frequente das mãos com água e sabão é a maneira mais eficaz de evitar o contágio.
8. Já existem mais de 150 artigos científicos
É o tempo da ciência e da cooperação. Em pouco mais de um mês, 164 artigos já podem ser consultados no PubMed sobre covid-19 ou SARSCov2, além de muitos outros disponíveis nos bancos de artigos ainda não revisados (pré-impressões).
São trabalhos preliminares sobre vacinas, tratamentos, epidemiologia, genética e filogenia, diagnóstico e aspectos clínicos.
Esses artigos foram preparados por cerca de 700 autores espalhados pelo planeta. É ciência em comum, compartilhada e aberta. Em 2003, quando a Sars aconteceu, levou mais de um ano para obter menos da metade de artigos.
9. Já existem protótipos de vacinas
Nossa capacidade de projetar novas vacinas é espetacular. Já existem mais de oito projetos contra o novo coronavírus. Existem grupos que trabalham em projetos de vacinas contra outros vírus semelhantes e agora tentam adaptar as pesquisas.
O que pode prolongar seu desenvolvimento são todos os testes necessários de toxicidade, efeitos colaterais, segurança, imunogenicidade e eficácia na proteção. É por isso que se fala em vários meses ou anos, mas alguns protótipos já estão em andamento.
Por exemplo, a vacina mRNA-1273 da empresa Moderna consiste em um fragmento de RNA mensageiro que codifica uma proteína derivada da glicoproteína S da superfície do coronavírus. Esta empresa possui protótipos semelhantes para outros vírus.
A Inovio Pharmaceuticals anunciou uma vacina de DNA sintético para o novo coronavírus, INO-4800, também baseada no gene S da superfície do vírus. Por sua vez, a Sanofi usará sua plataforma de expressão de baculovírus recombinante para produzir grandes quantidades do antígeno de superfície do novo coronavírus.
O grupo de vacinas da Universidade de Queensland, na Austrália, anunciou que já está trabalhando em um protótipo usando a técnica chamada “grampo molecular”, uma nova tecnologia que permite produzir vacinas usando o genoma do vírus em tempo recorde.
Na Espanha, o grupo de Luis Enjuanes e Isabel Sola, do CNB-CSIC, trabalha com vacinas contra coronavírus há anos.
Alguns desses protótipos serão testados em breve em humanos.
10. Existem mais de 80 ensaios clínicos com antivirais em andamento
As vacinas são preventivas. Mais importantes são os possíveis tratamentos de pessoas que já estão doentes. Já existem mais de 80 ensaios clínicos para analisar tratamentos contra coronavírus.
São antivirais que foram usados ??para outras infecções, já aprovados e que sabemos que são seguros.
Um dos que já foram testados em humanos é o remdesivir, um antiviral de amplo espectro, ainda em estudo, que foi testado contra Ebola e Sars/Mers. É um análogo da adenosina que é incorporado na cadeia do RNA viral e inibe sua replicação.
Outro candidato é a cloroquina, um antimalárico que também possui atividade antiviral potente. Sabe-se que bloqueia a infecção aumentando o pH do endossomo necessário para a fusão do vírus com a célula, o que inibe sua entrada.
Está provado que este composto bloqueia o novo coronavírus in vitro e já está sendo usado em pacientes que tiveram pneumonia devido ao vírus.
Lopinavir e Ritonavir são dois inibidores de protease usados ??como terapia antiretroviral que inibem a maturação final do vírus da Aids. Como a protease SARSCov2 demonstrou ser semelhante à do HIV, essa combinação já foi testada em pacientes com coronavírus.
Outros estudos propostos são baseados no uso de oseltamivir (um inibidor da neuraminidase usado contra o vírus da gripe), interferon-1b ??(proteína com função antiviral), anti-soros de pessoas já recuperadas e anticorpos monoclonais para neutralizar o vírus. Já foram sugeridas novas terapias com substâncias inibidoras, como a baricitinibina, selecionadas mediante inteligência artificial.
A pandemia de gripe de 1918 causou mais de 25 milhões de mortes em menos de 25 semanas. Algo semelhante poderia acontecer novamente hoje? Como vemos, provavelmente não. Nunca estivemos tão preparados para combater uma pandemia.
*Ignacio López-Goñi é professor de microbiologia na Universidade de Navarra, Espanha, e seu artigo original apareceu em The Conversation












